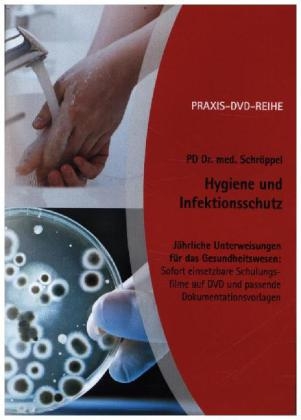
PRAXIS-DVD-Reihe J&auml;hrliche Unterweisungen f&uuml;r das Gesundheitswesen: Hygiene und Infektionsschutz -  Schr&ouml;ppel

PRAXIS-DVD-Reihe Jährliche Unterweisungen für das Gesundheitswesen: Hygiene und Infektionsschutz
2013
Forum Verlag Herkert (Hersteller)
978-3-86586-447-5 (ISBN)
Forum Verlag Herkert (Hersteller)
978-3-86586-447-5 (ISBN)
Zu diesem Artikel existiert eine Nachauflage
Jeder Arbeitgeber muss neue Mitarbeiter bei Arbeits-beginn und alle Mitarbeiter jährlich unterweisen. Die Unterweisung zu Hygiene und Infektionsschutz ist u. a. durch die Biostoffverordnung und die TRBA 250 vorgeschrieben.
| Verlagsort | Merching |
|---|---|
| Sprache | deutsch |
| Gewicht | 87 g |
| Einbandart | DVD-Box |
| Themenwelt | Medizin / Pharmazie |
| Schlagworte | Hygiene und Infektionsschutz • PRAXIS-DVD: Unterweisungen • TRBA 250 • Unterweisungs-DVD Hygiene und Infektionsschutz |
| ISBN-10 | 3-86586-447-3 / 3865864473 |
| ISBN-13 | 978-3-86586-447-5 / 9783865864475 |
| Zustand | Neuware |
| Informationen gemäß Produktsicherheitsverordnung (GPSR) | |
| Haben Sie eine Frage zum Produkt? |
